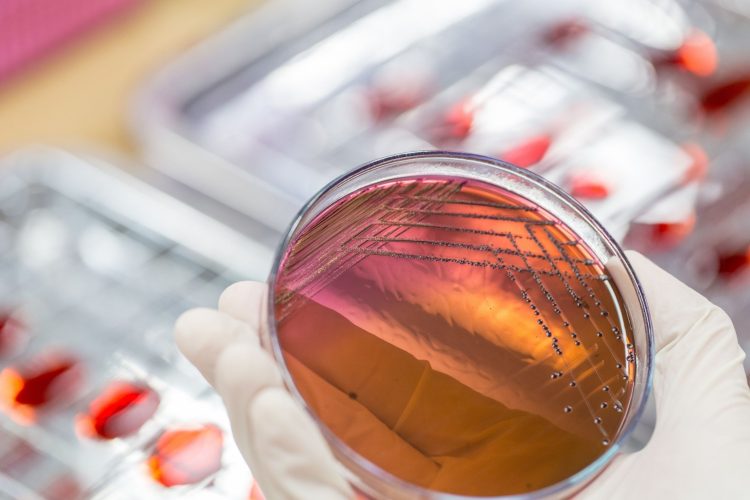
Υπερμικρόβια: Οι θάνατοι μπορεί να φτάσουν τα 8 εκατομμύρια έως το 2050

Η ανάπτυξη νέων φαρμάκων για την αντιμετώπιση των ανθεκτικών μικροβίων παραμένει «ανησυχητικά περιορισμένη», καθώς τα έργα αντιμικροβιακής έρευνας από μεγάλες φαρμακευτικές εταιρείες έχουν μειωθεί κατά 35% τα τελευταία πέντε χρόνια, σύμφωνα με έκθεση του Ιδρύματος Πρόσβασης στο Φάρμακο (AMF). Τα υπό ανάπτυξη φάρμακα μειώθηκαν από 92 σε 60, ενώ μόλις πέντε αφορούν παιδιά κάτω των πέντε ετών.
Η μικροβιακή αντοχή θεωρείται μία από τις μεγαλύτερες απειλές για την παγκόσμια υγεία. Σήμερα περισσότεροι από 1 εκατομμύριο άνθρωποι πεθαίνουν κάθε χρόνο από λοιμώξεις ανθεκτικές στα φάρμακα, ενώ συνολικά συνδέονται με περίπου 4 εκατομμύρια θανάτους ετησίως. Οι ειδικοί προειδοποιούν ότι οι θάνατοι αυτοί μπορεί να ξεπεράσουν τα 8 εκατομμύρια έως το 2050.
Μόνο λίγες μεγάλες φαρμακευτικές εταιρείες, όπως η GSK, η Shionogi και η Otsuka, συνεχίζουν να επενδύουν σημαντικά στην ανάπτυξη αντιβιοτικών. Παράλληλα, ειδικοί τονίζουν την ανάγκη για περισσότερη έρευνα, συντονισμένες επενδύσεις και περιορισμό της υπερβολικής χρήσης αντιβιοτικών, ιδιαίτερα στην ιατρική και την παραγωγή τροφίμων.
Ο Παγκόσμιος Οργανισμός Υγείας αναφέρει ότι μία στις έξι βακτηριακές λοιμώξεις που επιβεβαιώθηκαν εργαστηριακά το 2023 ήταν ανθεκτική στα αντιβιοτικά, γεγονός που υπογραμμίζει την επείγουσα ανάγκη για νέες θεραπείες.
Πληροφορίες από theguardian.com